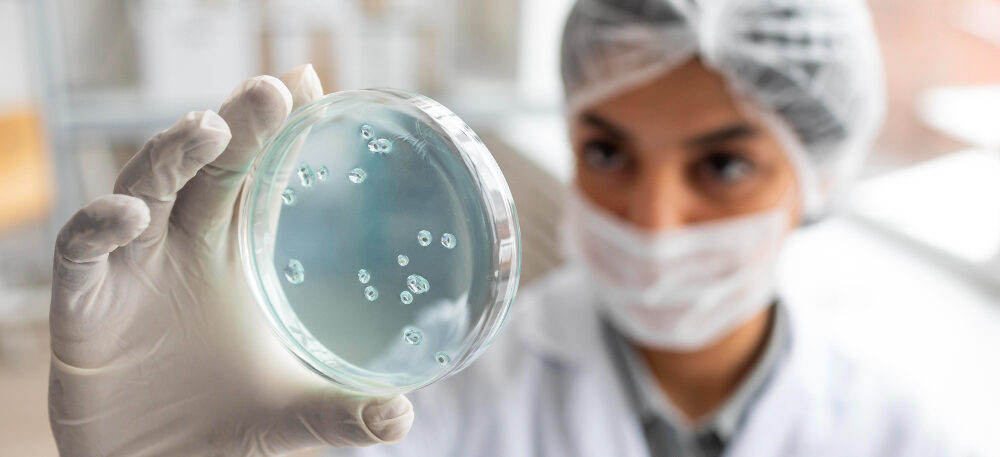
2148882109

Taller de Difusión de Resultados del proyecto “Estimación del riesgo de transmisión de enterobacterias multirresistentes a los antibióticos entre animales de producción, mascotas, humanos y el ambiente”
Se realizará de manera virtual el 14 de enero desde las 9:30 de la mañana.
Invitamos a la comunidad académica, científica y al público interesado a participar en el Taller de Difusión de Resultados del proyecto de investigación orientado a comprender y enfrentar uno de los principales desafíos actuales en salud pública: la resistencia antimicrobiana.
Este proyecto analiza el riesgo de transmisión de enterobacterias multirresistentes a los antibióticos desde un enfoque integral, considerando la interacción entre animales de producción, mascotas, humanos y el ambiente, bajo el enfoque Una Salud (One Health). Los resultados permitirán fortalecer la generación de evidencia científica para la toma de decisiones y el diseño de estrategias de prevención y control.
El taller será un espacio para conocer los principales hallazgos del proyecto, dialogar sobre sus implicancias en la salud pública, la salud animal y la protección del ambiente, y reflexionar sobre la importancia de la investigación científica frente a la resistencia a los antibióticos.
Contrato: N.° PE501078124-2022
Fecha: Miércoles 14 de enero de 2026
Hora: 9:30 a. m.
Modalidad: Virtual (Zoom)
Mira el programa:



